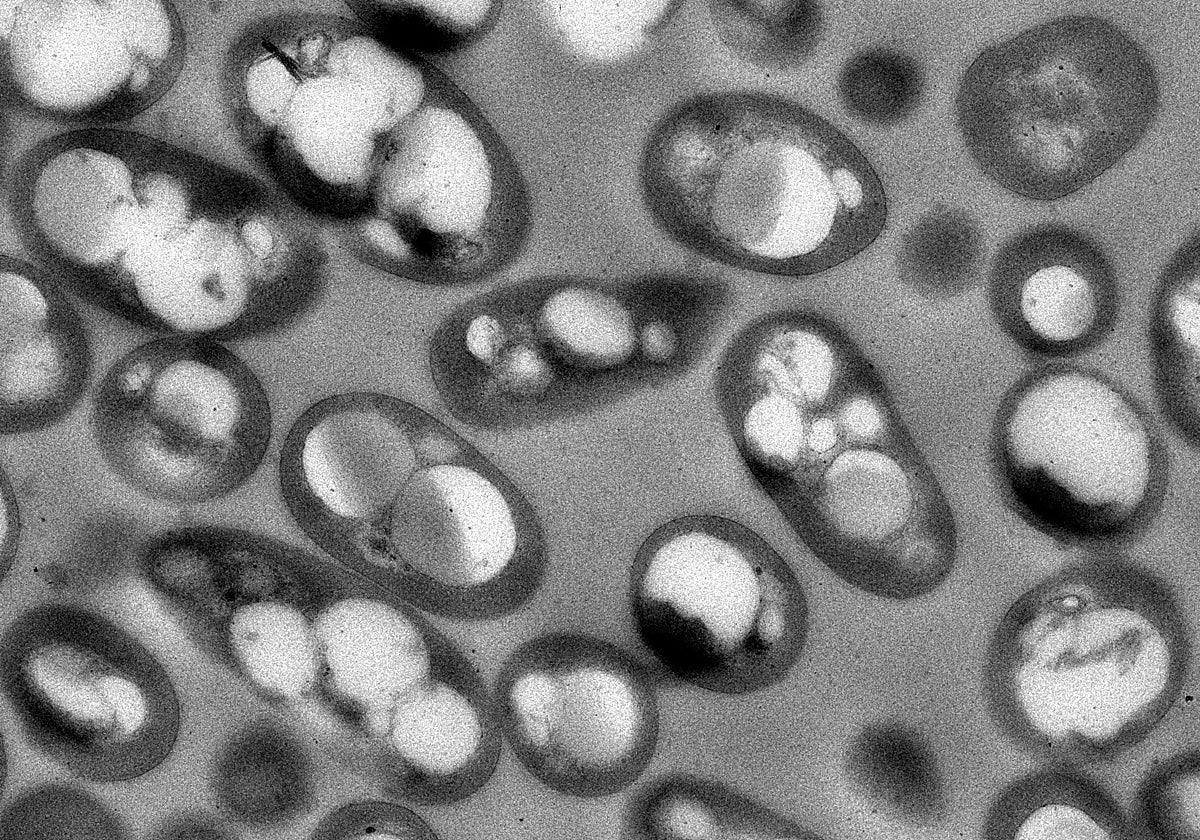
Bacterias diseñadas produciendo bioplástico.

investigación
Factorías bacterianas para producir bioplásticos
Un estudio del CSIC diseña cepas de una bacteria capaces de utilizar residuos plásticos como nutrientes para lograr bioplásticos degradables o compostables
NATURAL
Madrid
Investigadores del Consejo Superior de Investigaciones Científicas (CSIC) han logrado diseñar, mediante métodos computacionales y biología sintética, un conjunto de bacterias con la capacidad de producir bioplásticos bacterianos (polihidroxialcanoatos o PHAs) mediante el uso de materiales recalcitrantes, como hidrolizados de tereftalato de polietileno (PET), que ... es uno de los plásticos más empleados en envases y botellas, y derivados de lignina, uno de los polímeros más abundantes en la naturaleza y que hasta ahora es difícil de valorizar. Estas nuevas cepas y el bioproceso implementado como prueba de concepto se presentan en un trabajo publicado en la revista Cell Reports, que demuestra que tienen el potencial de convertirse en una herramienta sostenible para la gestión y revalorización de residuos plásticos, transformándolos en bioplásticos biodegradables o compostables.
El estudio, resultado de una colaboración entre el grupo de Biotecnología de Polímeros del Centro de Investigaciones Biológicas Margarita Salas (CIB-CSIC), liderado por Auxiliadora Prieto, y el grupo de Biotecnología de Sistemas del Centro Nacional de Biotecnología (CNB-CSIC) dirigido por Juan Nogales, ha implementado un enfoque multidisciplinar para superar los numerosos retos científico-técnicos que dificultaban la producción de PHAs a partir de materias primas, cuya estructura química no se relaciona con la del bioplástico.
En el contexto de la actual de crisis climática y la emergente economía circular, un objetivo fundamental es reemplazar los plásticos actuales basados en fuentes fósiles por alternativas más sostenibles y biodegradables como los PHAs. Estos compuestos, producidos por muchas bacterias, tienen amplias aplicaciones en medicina y en el sector del embalaje, y se consideran una alternativa viable a los plásticos derivados de combustibles fósiles. Los PHAs se almacenan como gránulos de reserva intracelular, sin embargo, su producción presenta un desafío significativo debido a la necesidad de inducir limitación de nutrientes, típicamente nitrógeno, fósforo u oxígeno, en el medio de cultivo para su producción. Esto representa un cuello de botella importante en la producción de PHAs, ya que requiere la implementación de bioprocesos complejos.
En este trabajo liderado por el CSIC se superan en gran medida estos obstáculos. En una primera instancia, se ha conseguido optimizar la producción de PHA reconfigurando el metabolismo bacteriano según predicciones computacionales. Finalmente, utilizando biología sintética, se ha logrado implementar una producción independiente de limitaciones nutricionales, lo que permite implantar bioprocesos más simples y eficientes. En palabras de María Manoli, primera firmante del trabajo y perteneciente al CIB-CSIC, «las factorías bacterianas desarrolladas han mostrado a escala de laboratorio la mayor producción de PHA en relación a la biomasa celular a partir de hidrolizados de PET jamás reportada». Además, añade, «las cepas desarrolladas fueron capaces de producir cantidades significativas de PHA a partir de otros residuos, como derivados de lignina, un polímero vegetal altamente recalcitrante».
En su conjunto, «estos resultados representan un avance muy significativo en el abordaje de la actual crisis global ocasionada por la acumulación de plástico en el medio ambiente y muestran cómo un enfoque multidisciplinar, que incluye predicciones computacionales, ingeniería genética y biología sintética permite poner en valor residuos difíciles de procesar en bioplásticos sostenibles y biodegradables», destaca Nogales. «Este cambio en la producción no solo podría reducir la huella de carbono en la producción de plásticos, sino también contribuir a mitigar la crisis del plástico, que tiene un costo de hasta 600.000 millones de dólares cada año», remarca.
Este trabajo ha dado lugar a una patente y se ha desarrollado en el contexto de dos proyectos europeos de Horizonte 2020: P4SB, en el que participaron 12 instituciones y empresas de cinco países, y MIX-UP, un proyecto en curso, en colaboración con China, que incluye la participación de diez instituciones y empresas europeas y cuatro instituciones chinas.
Esta funcionalidad es sólo para suscriptores
Suscribete
Esta funcionalidad es sólo para registrados
Iniciar sesiónEsta funcionalidad es sólo para suscriptores
Suscribete